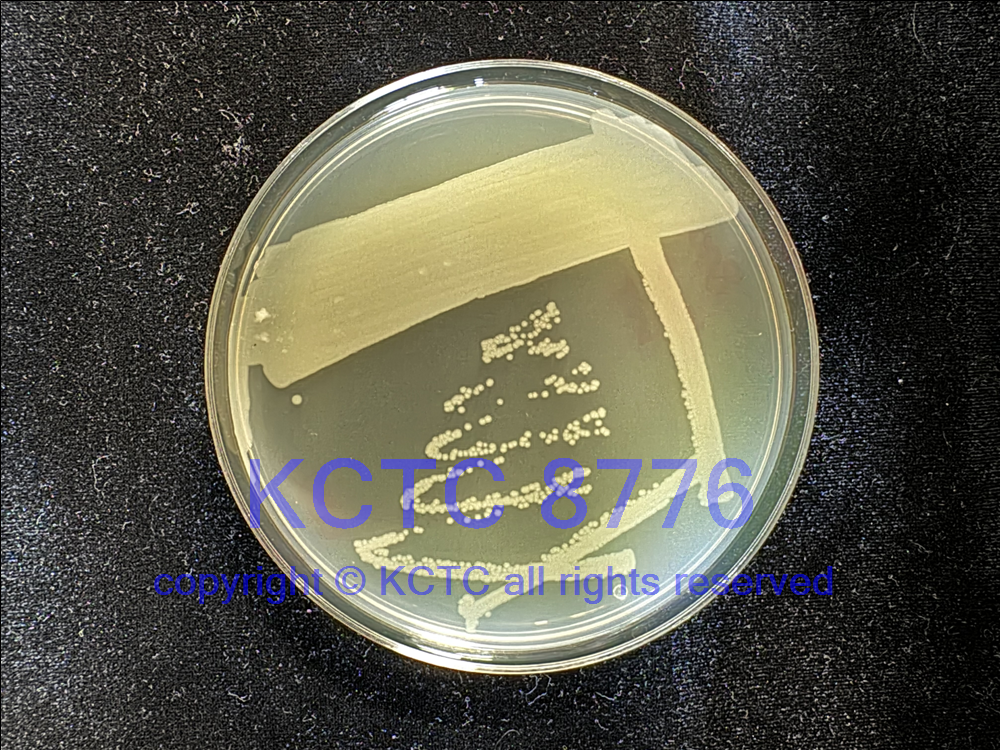

KCTC No. 8776
(KCTC Other No.)
Resource Type Bacteria
Name Pseudomonas abietaniphila
Type Strain Yes
Biosafty Level 1
LMO No
Synonym
Phylum (ex Phylum) Pseudomonadota (Proteobacteria - Gammaproteobacteria)
Genome Information
History <- DSMZ <- W. W. Mohn <- P. Bicho; BKME-9
Source From Bleached kraft mill effluent, Kamloops, B.C., Canada
Other Collection No. BKME-9, DSM [17554], ATCC [700689], CIP [106708]
Reference DOI: 10.1016/S0723-2020(99)80029-0
KCTC Media No. KCTC media No. 774 TSA medium
Oxygen Requirement Aerobic
Temperature 28 ℃
pH netural pH ?? ?? (???? ??)
Incubation Time 3d [???? ???? ????? ??, ?? ? ????? ??? ?? ?? ? ??]
KCTC8776